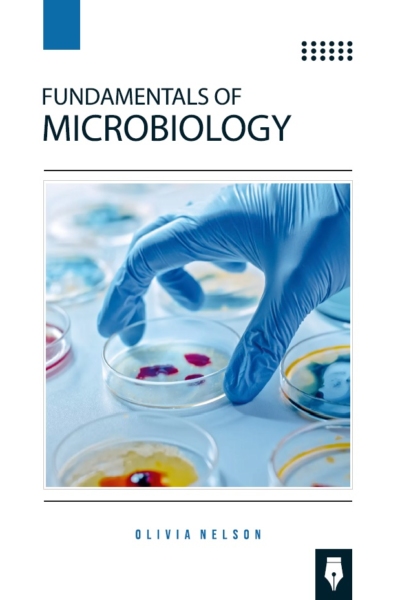
Fundamentals of Microbiology

Add to WishlistRemove from Wishlist
Add to Wishlist
Industrial Biochemistry
Author: Jacob Reese
Additional information
| Pages | 335 Pages |
|---|---|
| Publisher | |
| Language | English |
| ISBN | 979-8-89161-123-8 |
| Publishing Year | 2024 |
| Subject | Biochemistry |
Only logged in customers who have purchased this product may leave a review.

Reviews
There are no reviews yet.